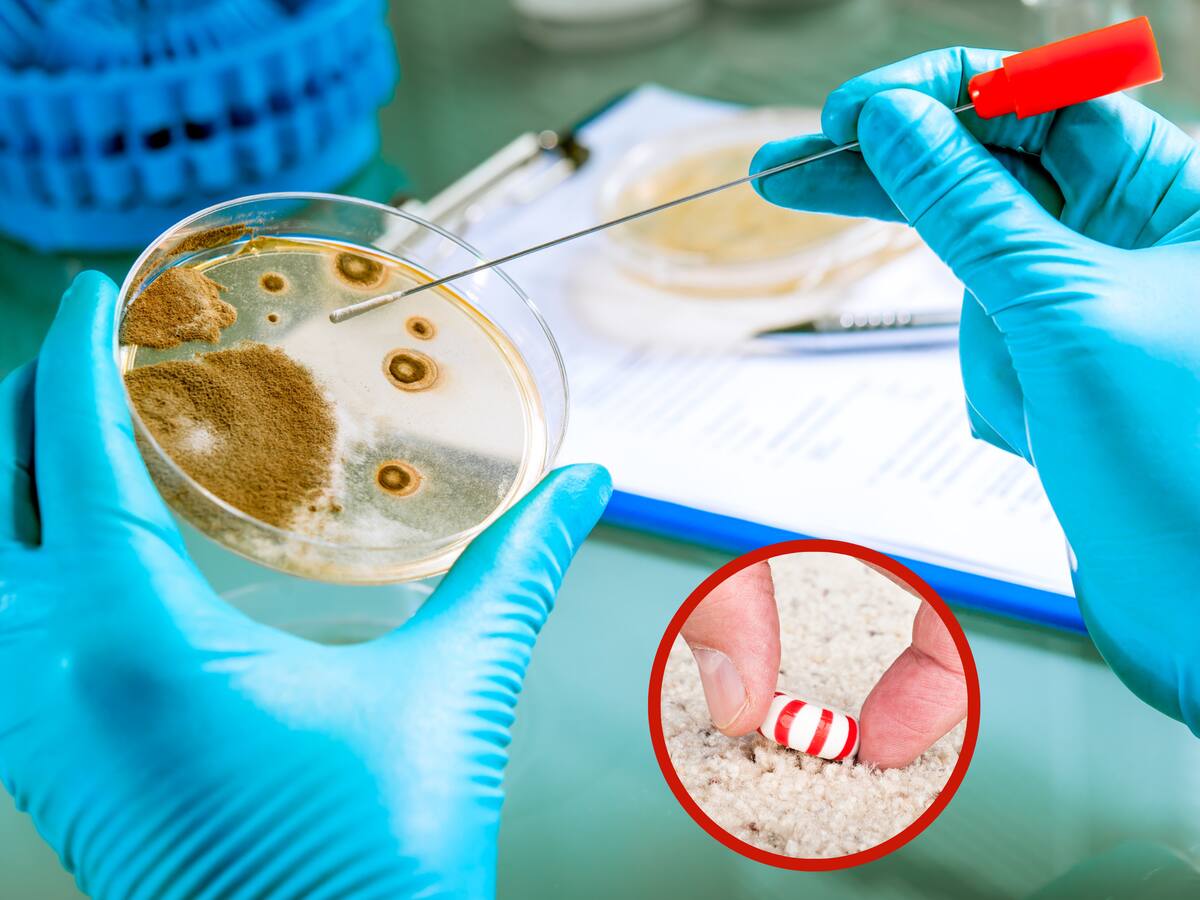
¿La regla de los 5 segundos es cierta? La ciencia reveló la verdad de este mito

Superbacterias: alertan propagación de gen que crea bacterias resistentes a los antibióticos
El gen npmA2 ha sido identificado en seis países y se alerta que no solo se transmite entre humanos sino también animales.
17/07/2025 - 07:58
Eddy Mosquera | EFE